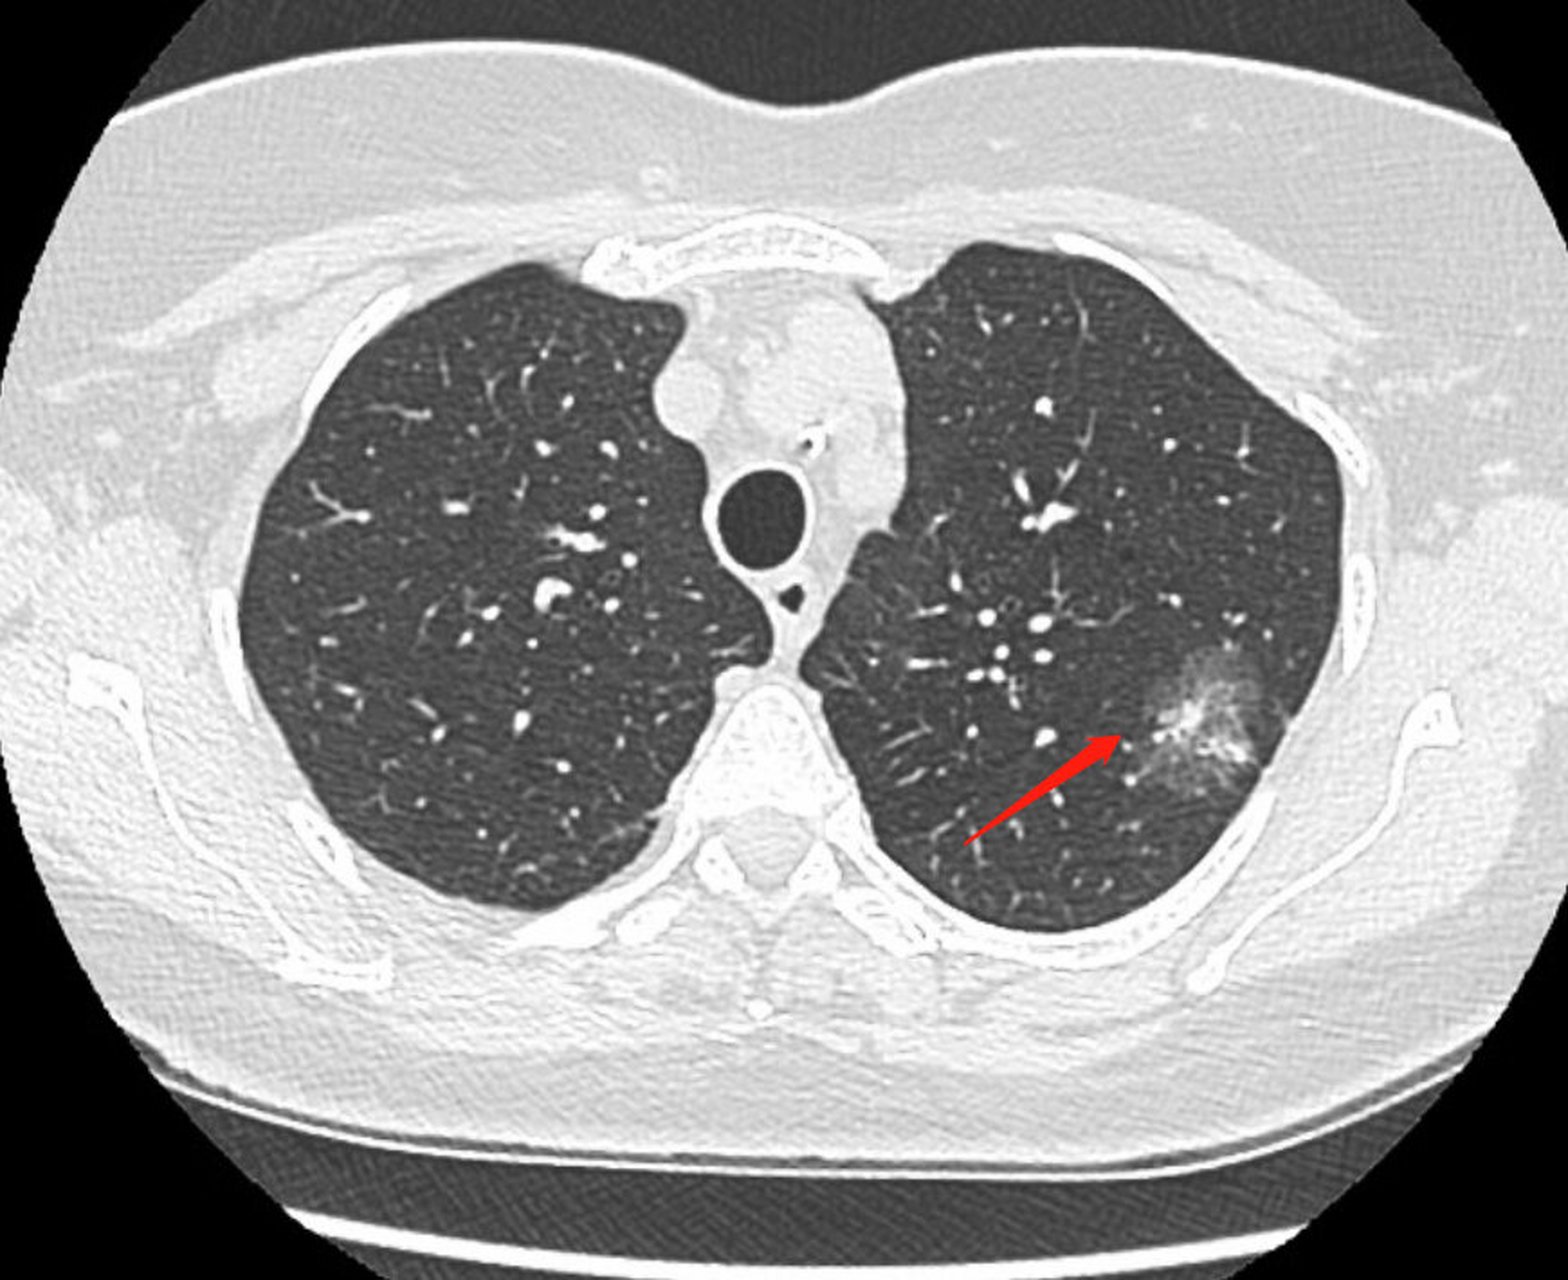
肺癌对应的ct影像-1 很多朋友问肺ct怎么看,以及肺癌影像有什么特点

ct影像图片

胸部ct平扫图片,金典=== - 医学影像学讨论版 - 爱爱医医学论坛
图片尺寸512x666
病例金葡菌性肺炎1例ct影像表现
图片尺寸512x512
自己的肺部ct老师们帮看下 - 医学影像学讨论版 - 爱爱医医学论坛
图片尺寸662x662
【影像读片】看到19岁姑娘这样的ct,你会怎么办?
图片尺寸3824x3064
典型吸烟导致肺癌的ct图像,2.9cm肺结节,有毛刺,分叶, - 抖音
图片尺寸1440x1920
年轻的生命-一个令人警醒的病例 - 医学影像学讨论版 - 爱爱医医学
图片尺寸2048x2048
支气管炎ct影像学表现为双肺纹理增粗,增多,纹理紊乱,双肺斑点状
图片尺寸1566x1280
肺部x线 ct(病理结果已公布) - 影像核医学 - 专业医生社区,医学,药学
图片尺寸1725x1659
ct眼壁钙化,帮忙看看,谢谢. - 医学影像学讨论版 - 爱爱医医学论坛
图片尺寸2048x1536
肺癌对应的ct影像-1 很多朋友问肺ct怎么看,以及肺癌影像有什么特点
图片尺寸1568x1280
鹦鹉热衣原体肺炎1例ct影像表现
图片尺寸640x986
临床检查区 69 医学影像学讨论版 69 大家都来看看这个眼ct
图片尺寸2560x1920
胃平滑肌肉瘤1例ct影像
图片尺寸1024x1515
ct右肺胸膜发现了什么? - 医学影像学讨论版 - 爱爱医医学论坛
图片尺寸2842x2136
【影像读片】分享一例典型结节病的ct和气管镜表现
图片尺寸2500x2560
【影像读片】经典ct,谁能说全(结果已公布)
图片尺寸2048x1536
帮忙给看下ct片子,请问哪里病变了.是不是有点突出?应该怎么治疗.
图片尺寸3072x2304
论坛 69 ★临床检查区 69 医学影像学讨论版 69 胸部x射线 ct
图片尺寸1944x2592![【影像读片】没见这样胸部ct,请专家分析 [病例帖]](https://imgs.wantubizhi.com/img/A1A61BAA66193547F3A6DD7D8EE527E97548C1A7A6F13DBFC508FE41CBD5B4AB585987DBA85DFFE322BF4076211C5C00FEF475600261D44F3495FA3389B1B3035237E433F4CAA9F450424CCC51F72DD73C39FA31D63BE0F95A93C0C52FCA32B8)
【影像读片】没见这样胸部ct,请专家分析 [病例帖]
图片尺寸2040x2441
肝脏ct/20100622/随访 - 医学影像学讨论版 - 爱爱医医学论坛 - 爱爱
图片尺寸2102x1920
猜你喜欢:正常ct胸片影像图片影像图片ct图片ct影像拍ct图片肩膀ct正常影像图片肺大泡ct影像图片ct室图片垂体瘤ct影像图片全身ct图片正常肺ct片图片图解ct检查图片正常的肺部ct影像图片肺癌影像图片盆腔ct图片食管癌ct影像图片倒车影像图片腹部ct图片结核ct影像表现图片医院ct图片肺部ct图片肺结核ct片图片图解健康人的ct胸片图片医学影像图片脑出血ct影像表现图片膈疝ct表现影像图腰椎正常ct影像图肺癌ct图片肝硬化ct影像表现图片脑梗图片ct儿童手工制作风筝海鱼 扁扁的胆结石手术少林寺三宝个人资料张雨生太平间打包盒大小班画画图片大全潇洒的图片霸气锦绣前程书法作品邀月演员于莉d700尼康刘辽逸

![【影像读片】没见这样胸部ct,请专家分析 [病例帖]](https://img.dxycdn.com/upload/2007/11/07/15190075.jpg)
